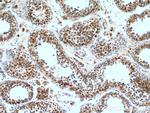
CCP1 Antibody in Immunohistochemistry (Paraffin) (IHC (P))
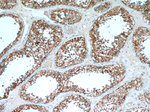
CCP1 Antibody in Immunohistochemistry (Paraffin) (IHC (P))

Search
Proteintech
CCP1 Polyclonal Antibody
{{$productOrderCtrl.translations['antibody.pdp.commerceCard.promotion.promotions']}}
{{$productOrderCtrl.translations['antibody.pdp.commerceCard.promotion.viewpromo']}}
{{$productOrderCtrl.translations['antibody.pdp.commerceCard.promotion.promocode']}}: {{promo.promoCode}} {{promo.promoTitle}} {{promo.promoDescription}}. {{$productOrderCtrl.translations['antibody.pdp.commerceCard.promotion.learnmore']}}
产品信息
14067-1-AP
种属反应
已发表种属
宿主/亚型
分类
类型
抗原
偶联物
形式
浓度
规格
纯化类型
保存液
内含物
保存条件
运输条件
产品详细信息
Immunogen sequence: VLCETLSGN SCPLVTITAM PESNYYEHIC HFRNRPYVFL SARVHPGETN ASWVMKGTLE YLMSNNPTAQ SLRESYIFKI VPMLNPDGVI NGNHRCSLSG EDLNRQWQSP SPDLHPTIYH AKGLLQYLAA VKRLPLVYCD YHGHSRKKNV FMYGCSIKET VWHTNDNATS CDVVEDTGYR TLPKILSHIA PAFCMSSCSF VVEKSKESTA RVVVWREIGV QRSYTMESTL CGCDQGKYKG LQIGTRELEE MGAKFCVGLL RLKRLTSPLE YNLPSSLLDF ENDLIESSCK VTSPTTYVLD EDEPRFLEEV DYSAESNDEL DIELAENVGD YEPSAQEEVL SDSELSRTYL P (837-1186 aa encoded by BC060815)
靶标信息
NNA1 is a zinc carboxypeptidase that contains nuclear localization signals and an ATP/GTP-binding motif that was initially cloned from regenerating spinal cord neurons of the mouse.
仅用于科研。不用于诊断过程。未经明确授权不得转售。
生物信息学
蛋白别名: ATP/GTP binding protein 1; ATP/GTP-binding protein 1; carboxypeptidase-tubulin; Cytosolic carboxypeptidase 1; DKFZp686M20191; Nervous system nuclear protein induced by axotomy protein 1; Nervous system nuclear protein induced by axotomy protein 1 homolog; nuclear ATP/GTP-binding protein; Protein deglutamylase CCP1; Purkinje cell degeneration; soluble carboxypeptidase; tubulinyl-Tyr carboxypeptidase; tyrosine carboxypeptidase; unnamed protein product
基因别名: 1700020N17Rik; 2310001G17Rik; 2900054O13Rik; 4930445M19Rik; 5730402G09Rik; AGTPBP1; CCP1; CONDCA; KIAA1035; nmf243; NNA1; pcd
UniProt ID: (Human) Q9UPW5, (Mouse) Q641K1
Entrez Gene ID: (Human) 23287, (Mouse) 67269